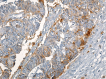

Pathological and immunohistochemical study of colon cancer. Evaluation of markers for colon cancer stem cells
- PMID: 34609414
- PMCID: PMC8597393
- DOI: 10.47162/RJME.62.1.11
Pathological and immunohistochemical study of colon cancer. Evaluation of markers for colon cancer stem cells
Abstract
Colorectal cancer is a major public health problem worldwide with increasing morbidity and mortality. Numerous exogenous and endogenous factors are involved in colorectal carcinogenesis: age, sex, diet, smoking, alcohol consumption, exposure to harmful environmental factors, intestinal microbiota, bacterial and viral infections, the ability of the host immune system to respond, genetic factors, etc. The present study analyzed histopathologically and immunohistochemically a number of 36 cases of colorectal adenocarcinomas. The existence of an accentuated cell pleomorphism was noted, which corresponds to different clones of tumor cells, in the same tumor coexisting aspects of tubular adenocarcinoma, mucinous areas and even signet-ring cell. The tumor stroma was mainly of the desmoplastic type, but also of the lax type, more or less infiltrated with inflammatory cells. Evaluation of immunomarkers for cancer stem cells (CSCs) showed that none of the markers used alone [cluster of differentiation (CD)133, CD44, aldehyde dehydrogenase 1 family member A1 (ALDH1A1), CD24, CD26] show CSCs.
Conflict of interest statement
The authors declare that they have no conflict of interests.
Figures

References
-
- Siegel RL, Miller KD, Jemal A. Cancer statistics, 2018. CA Cancer J Clin. 2018;68(1):7–30. - PubMed
-
- Bray F, Ferlay J, Soerjomataram I, Siegel RL, Torre LA, Jemal A. Global cancer statistics 2018: GLOBOCAN estimates of incidence and mortality worldwide for 36 cancers in 185 countries. CA Cancer J Clin. 2018;2020;6870(6)(4):394–424. 313–313. - PubMed
MeSH terms
LinkOut - more resources
Full Text Sources
Medical
Research Materials
Miscellaneous

